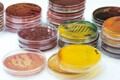

Connecting the dots: Brenntag rolls out global food and nutrition brand
Brenntag says the launch of its global Food & Nutrition brand will help new and existing customers to connect the dots in NPD and formulation, adding it is global network is ‘perfectly positioned’ to meet help with product concepts and technical development.